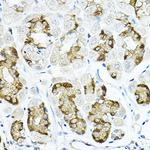
LRRC59 Antibody in Immunohistochemistry (Paraffin) (IHC (P))

Search
Invitrogen
LRRC59 Polyclonal Antibody
{{$productOrderCtrl.translations['antibody.pdp.commerceCard.promotion.promotions']}}
{{$productOrderCtrl.translations['antibody.pdp.commerceCard.promotion.viewpromo']}}
{{$productOrderCtrl.translations['antibody.pdp.commerceCard.promotion.promocode']}}: {{promo.promoCode}} {{promo.promoTitle}} {{promo.promoDescription}}. {{$productOrderCtrl.translations['antibody.pdp.commerceCard.promotion.learnmore']}}
图: 1 / 4
LRRC59 Antibody (PA5-87571) in IHC (P)

Please note: We are reviewing Western blot images included in the antibody testing data in our catalog, including those provided by third parties. Unless expressly labeled or annotated as “raw-unedited”, Western blot images included in the antibody testing data in our catalog may have been edited, optimized or otherwise adjusted for presentation.
产品信息
PA5-87571
种属反应
宿主/亚型
分类
类型
抗原
偶联物
形式
浓度
规格
纯化类型
保存液
内含物
保存条件
运输条件
RRID
产品详细信息
Immunogen sequence: MTKAGSKGGN LRDKLDGNEL DLSLSDLNEV PVKELAALPK ATILDLSCNK LTTLPSDFCG LTHLVKLDLS KNKLQQLPAD FGRLVNLQHL DLLNNKLVTL PVSFAQLKNL KWLDLKDNPL DPVLAKVAGD CLDEKQCKQC ANKVLQHMKA VQADQERERQ RRLEVEREAE KKREAKQRAK EAQERELRKR EKAEEKERRR KEYDALKAAK REQEKKPKKE ANQAPKSKSG SRPRKPPPRK HTRS; Positive Samples: HeLa, SH-SY5Y, BT-474, HepG2, NIH/3T3, Mouse liver, Rat liver; Cellular Location: Endoplasmic reticulum membrane, Microsome membrane, Nucleus envelope, Single-pass type II membrane protein
靶标信息
Required for nuclear import of FGF1, but not that of FGF2. Might regulate nuclear import of exogenous FGF1 by facilitating interaction with the nuclear import machinery and by transporting cytosolic FGF1 to, and possibly through, the nuclear pores. [UniProt]
仅用于科研。不用于诊断过程。未经明确授权不得转售。
篇参考文献 (0)
生物信息学
蛋白别名: Leucine-rich repeat-containing protein 59; Protein p34
基因别名: AA959742; C78668; Lrrc59; Rbp34
UniProt ID: (Mouse) Q922Q8, (Rat) Q5RJR8
Entrez Gene ID: (Mouse) 98238, (Rat) 287633




